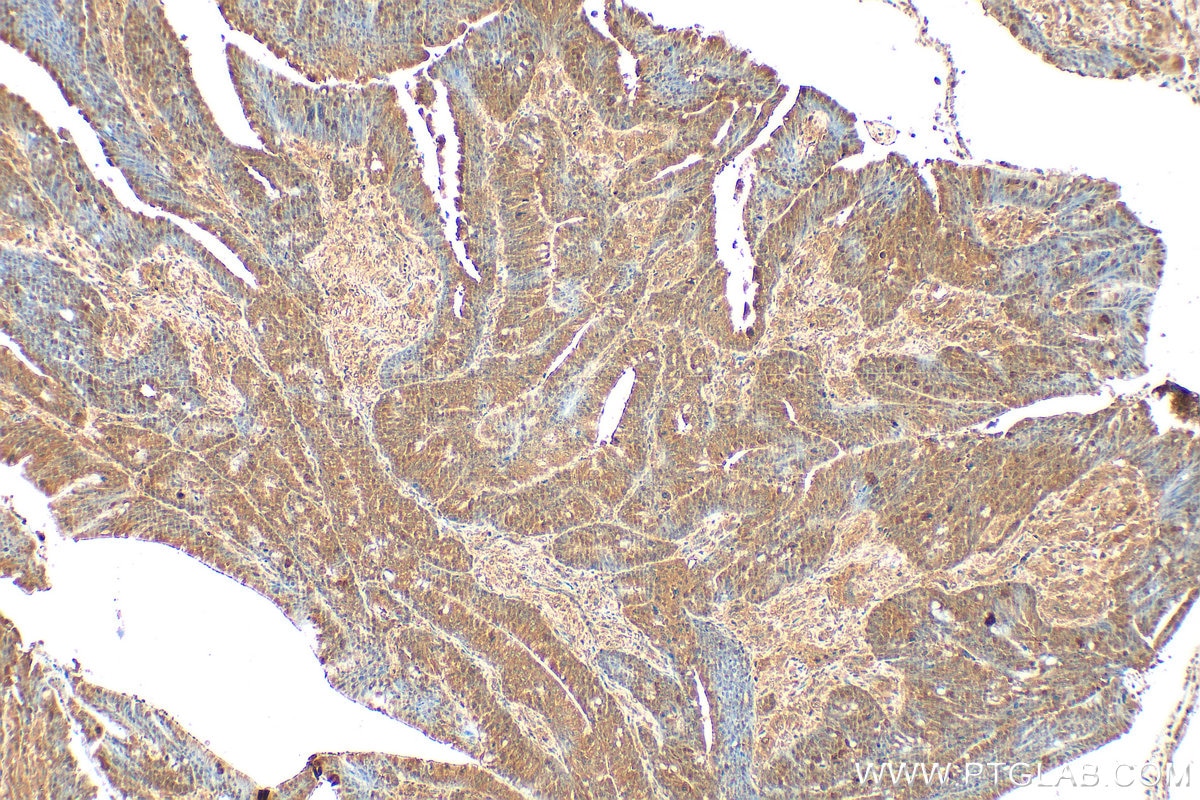
Immunohistochemistry (IHC) staining of human colon cancer tissue using RECQL4 Polyclonal antibody (17008-1-AP)

Validation Data Gallery
Tested Applications
| Positive WB detected in | HeLa cells, HepG2 cells |
| Positive IP detected in | HeLa cells |
| Positive IHC detected in | human gliomas tissue, human colon cancer tissue, human kidney tissue Note: suggested antigen retrieval with TE buffer pH 9.0; (*) Alternatively, antigen retrieval may be performed with citrate buffer pH 6.0 |
| Positive IF/ICC detected in | HeLa cells |
Recommended dilution
| Application | Dilution |
|---|---|
| Western Blot (WB) | WB : 1:1000-1:5000 |
| Immunoprecipitation (IP) | IP : 0.5-4.0 ug for 1.0-3.0 mg of total protein lysate |
| Immunohistochemistry (IHC) | IHC : 1:50-1:500 |
| Immunofluorescence (IF)/ICC | IF/ICC : 1:200-1:800 |
| It is recommended that this reagent should be titrated in each testing system to obtain optimal results. | |
| Sample-dependent, Check data in validation data gallery. | |
Published Applications
| KD/KO | See 3 publications below |
| WB | See 6 publications below |
| IHC | See 4 publications below |
| IF | See 3 publications below |
| IP | See 1 publications below |
Product Information
17008-1-AP targets RECQL4 in WB, IHC, IF/ICC, IP, ELISA applications and shows reactivity with human samples.
| Tested Reactivity | human |
| Cited Reactivity | human, mouse |
| Host / Isotype | Rabbit / IgG |
| Class | Polyclonal |
| Type | Antibody |
| Immunogen |
CatNo: Ag10707 Product name: Recombinant human RECQL4 protein Source: e coli.-derived, PGEX-4T Tag: GST Domain: 297-652 aa of BC013277 Sequence: CTCTCTRPPSEQEGAVGGERPVPKYPPQEAEQLSHQAAPGPRRVCMGHERALPIQLTVQALDMPEEAIETLLCYLELHPHHWLELLATTYTHCRLNCPGGPAQLQALAHRCPPLAVCLAQQLPEDPGQGSSSVEFDMVKLVDSMGWELASVRRALCQLQWDHEPRTGVRRGTGVLVEFSELAFHLRSPGDLTAEEKDQICDFLYGRVQARERQALARLRRTFQAFHSVAFPSCGPCLEQQDEERSTRLKDLLGRYFEEEEGQEPGGMEDAQGPEPGQARLQDWEDQVRCDIRQFLSLRPEEKFSSRAVARIFHGIGSPCYPAQVYGQDRRFWRKYLHLSFHALVGLATEELLQVAR 相同性解析による交差性が予測される生物種 |
| Full Name | RecQ protein-like 4 |
| Calculated molecular weight | 1208 aa, 133 kDa |
| Observed molecular weight | 145-150 kDa |
| GenBank accession number | BC013277 |
| Gene Symbol | RECQL4 |
| Gene ID (NCBI) | 9401 |
| RRID | AB_2238324 |
| Conjugate | Unconjugated |
| Form | |
| Form | Liquid |
| Purification Method | Antigen affinity purification |
| UNIPROT ID | O94761 |
| Storage Buffer | PBS with 0.02% sodium azide and 50% glycerol{{ptg:BufferTemp}}7.3 |
| Storage Conditions | Store at -20°C. Stable for one year after shipment. Aliquoting is unnecessary for -20oC storage. |
Background Information
RECQ protein-like 4(RECOL4), which has helicase domains contain 7 consensus motifs in the middle, is a gene responsible for Werner syndorme and Bloom syndrome. It forms a stable complex with UBR1 adn UBR2, which has a DNA-stimulated ATPase activity. RECOL4 may involve in repairment of DNA damage by interaction with APE1 and FEN1, key participants in base excision repair. This is a rabbit polyclonal antibody raised against part of C-terminal of RECQ4 of human origin. The calculated molecular weight of EIF3B is 133 kDa, but the modified EIF3B protein is about 145-150 kDa.
Protocols
| Product Specific Protocols | |
|---|---|
| IF protocol for RECQL4 antibody 17008-1-AP | Download protocol |
| IHC protocol for RECQL4 antibody 17008-1-AP | Download protocol |
| IP protocol for RECQL4 antibody 17008-1-AP | Download protocol |
| WB protocol for RECQL4 antibody 17008-1-AP | Download protocol |
| Standard Protocols | |
|---|---|
| Click here to view our Standard Protocols |
Publications
| Species | Application | Title |
|---|---|---|
Nat Commun DNA replication initiation factor RECQ4 possesses a role in antagonizing DNA replication initiation | ||
Cancer Biol Med RECQL4 regulates DNA damage response and redox homeostasis in esophageal cancer.
| ||
FASEB J UBE2O and USP7 co-regulate RECQL4 ubiquitinylation and homologous recombination-mediated DNA repair. | ||
J Biol Chem The Deubiquitinase USP28 Stabilizes Expression of RecQ Family Helicases and Maintains the Viability of Triple Negative Breast Cancer Cells. | ||
Sci Rep PARP1 regulates DNA damage-induced nucleolar-nucleoplasmic shuttling of WRN and XRCC1 in a toxicant and protein-specific manner. | ||
bioRxiv USP50 suppresses alternative RecQ helicase use and deleterious DNA2 activity during replication |